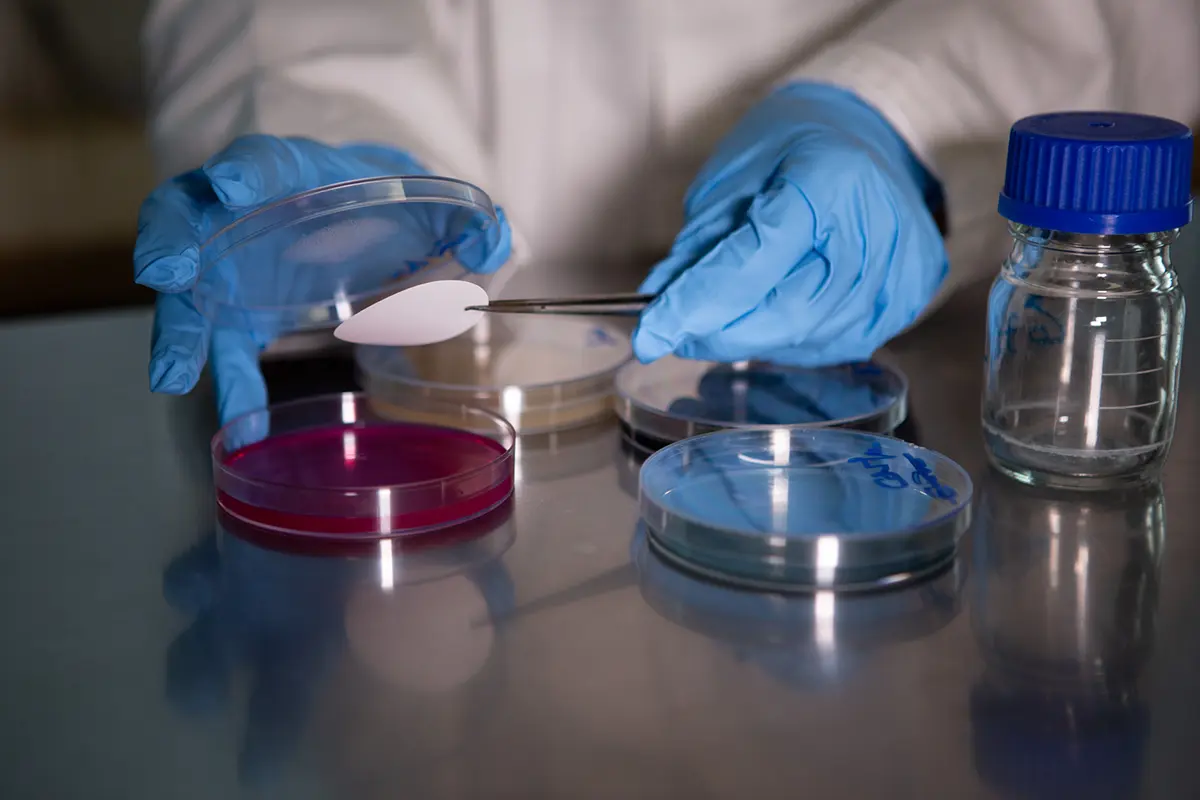

Da 40 anni, il punto di riferimento per la prevenzione a Bologna.
In quarant’anni i Laboratori Analisi Bio 5 si sono radicati a Bologna, creando per ciascun cliente un sistema integrato tra salute, sicurezza e ambiente per una migliore prevenzione nei luoghi di lavoro favorendo qualità ed efficienza.
Medicina del lavoro
Lorem ipsum dolor sit amet, consectetur adipiscing elit. Fusce ultricies vitae tellus sed lobortis. Duis risus erat, elementum in feugiat ac, maximus id mi. Sed in iaculis nisi.

Medico
competente
Scopri di più
Servizi di medicina del lavoro
Scopri di piùSicurezza
Lorem ipsum dolor sit amet, consectetur adipiscing elit. Fusce ultricies vitae tellus sed lobortis. Duis risus erat, elementum in feugiat ac, maximus id mi. Sed in iaculis nisi.

Valutazione
dei rischi
Scopri di più
Nomine
e incarichi
Scopri di più
Consulenze sulla sicurezza
Scopri di più
Ambiente
I nostri servizi ambientali specializzati comprendono l’analisi delle acque di superficie e sotterranee, dei suoli, dei sedimenti, dei fanghi, dei rifiuti liquidi e solidi e degli effluenti gassosi, degli ambienti indoor – outdoor, nonché delle emissioni industriali. Eseguiamo analisi chimico-fisiche e microbiologiche.
Qualificati nella gestione dei rifiuti, vi possiamo dare supporto anche nella corretta classificazione dei rifiuti destinati allo smaltimento finale nel rispetto degli standard di qualità ambientale secondo leggi e normative vigenti.
Laboratori
Lorem ipsum dolor sit amet, consectetur adipiscing elit. Fusce ultricies vitae tellus sed lobortis. Duis risus erat, elementum in feugiat ac, maximus id mi. Sed in iaculis nisi.

Laboratorio
clinico
Scopri di più
Laboratorio
chimico
Scopri di più
Laboratorio microbiologico
Scopri di piùCorsi
Professionalità, Competenza, Attenzione al Cliente e Affidabilità sono qualità che contraddistinguono le nostre attività formative. Ogni corso di formazione viene pianificato in base alle richieste del cliente.
Le lezioni di tipo frontale sono coadiuvate da strumenti informatici all’avanguardia, mentre alcune tipologie di corsi sono disponibili anche in versione E-Learning o in modalità Blending (una parte in E-Learning ed una parte di lezioni frontali).
Si precisa che, laddove richiesto, i corsi potranno essere pianificati anche presso la sede del Cliente, da programmarsi in base alle specifiche richieste.
- FORMAZIONE DEI LAVORATORI
- DPI TERZA CATEGORIA
- PRIMO SOCCORSO
- FORMAZIONE DEL ASPP-RSPP
- FORMAZIONE RELATIVA ALL’USO DI ATTREZZATURE DA LAVORO
- ANTINCENDIO
- CORSO DIISOCIANATI
- BLS-D
- ADDETTI AI LAVORI ELETTRICI – PES, PAV, PEI
- WELFARE E BENESSERE ORGANIZZATIVO
I prossimi corsi
Poliambulatorio
Le prestazioni medico-sanitarie del POLIAMBULATORIO BIO5 agiscono sia per la prevenzione che per la promozione della salute e del benessere, sia per la terapia delle patologie.
BIO 5 SALUTE nasce dall’esperienza e dalla professionalità di BIO 5, un punto di riferimento nel settore del benessere e della salute. Il nostro team è composto da medici specialisti, fisioterapisti, infermieri e personale di supporto altamente qualificato, costantemente aggiornato sulle più recenti scoperte scientifiche e sulle nuove tecnologie mediche.

Potrete prenotare online i servizi di:
FISIOTERAPIA E MEDICINA RIABILITATIVA (Ortopedia, Fisiatria, Medicina dello Sport)
ECOGRAFIE
VISITE MEDICHE SPECIALISTICHE E PRESTAZIONI SANITARIE:
Allergologia, Andrologia, Cardiologia, Dermatologia, Diabetologia, Gastroenterologia, Ginecologia, Medicina Interna, Nutrizione clinica e sportiva, Otorinolaringoiatria, Psicologia, Urologia.
CHECK UP E PERCORSI SALUTE
WELFARE AZIENDALE
Come raggiungerci
Il laboratorio analisi Bio 5 si trova in Via Corticella, 11/4 a Castel Maggiore, Bologna.
Per raggiungerci, dall’uscita n.5 della tangenziale procedi in direzione nordest lungo Via Cristoforo Colombo e continua dritto per circa 2,5 km, superando due rotonde. Alla Rotonda Martiri delle Foibe, prendi la terza uscita per imboccare Via Corticella.
Prosegui per qualche centinaio di metri, superando un’ulteriore rotonda, e poi svolta a destra.
Troverai il nostro poliambulatorio sulla sinistra.
